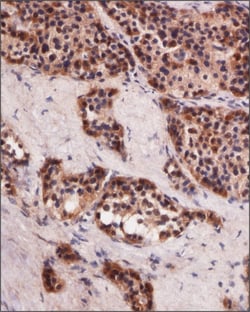
Invitrogen HB9 Polyclonal Antibody 100 &mu;g; Unconjugated:Anticorps, Polyclonal

missing translation for 'onlineSavingsMsg'
Learn More
Learn More
Invitrogen™ HB9 Polyclonal Antibody


Rabbit Polyclonal Antibody
Marque: Invitrogen™ PA523407
Les retours ne sont pas autorisés pour ce produit.
Afficher la politique du retour.
Description
HB9 Polyclonal Antibody for Western Blot, IHC (P), ICC/IF
Homeobox protein HB9 is expressed in lymphoid and pancreatic tissues. It is reported to be Putative transcription factor involved in pancreas development and function. Defects in this gene causes Currarino syndrome. The triad of a presacral tumor, sacral agenesis and anorectal malformation constitutes the Currarino syndrome which is caused by dorsal-ventral patterning defects during embryonic development. It is also reported that HB9 is strongly expressed in epidermal basal cells of the outer scale face in tarsometatarsal scale skin.
Spécification
| HB9 | |
| Polyclonal | |
| Unconjugated | |
| MNX1 | |
| HB9; Hlxb9; homeo box HB9; homeobox gene HB9; homeobox HB9; homeobox protein HB9; homeodomain protein Hb9; HOX SCRA1; HOXHB9; LOW QUALITY PROTEIN: motor neuron and pancreas homeobox protein 1; MNR2; MNX1; motor neuron and pancreas homeobox 1; motor neuron and pancreas homeobox protein 1; SCRA1; zgc:112174 | |
| Rabbit | |
| Antigen affinity chromatography | |
| RUO | |
| 15285, 3110 | |
| Store at 4°C short term. For long term storage, store at -20°C, avoiding freeze/thaw cycles. | |
| Liquid |
| Immunohistochemistry (Paraffin), Western Blot, Immunocytochemistry | |
| 1 mg/mL | |
| PBS with 0.02% sodium azide | |
| P50219, Q9QZW9 | |
| MNX1 | |
| A portion of amino acids 330-380 of mouse MNX1/HLXB9. | |
| 100 μg | |
| Primary | |
| Human, Mouse | |
| Antibody | |
| IgG |
Correction du contenu d'un produit
Veuillez fournir vos retours sur le contenu du produit en remplissant le formulaire ci-dessous.
Nom du produit
Vous avez repéré une opportunité d'amélioration ?Partager une correction de contenu